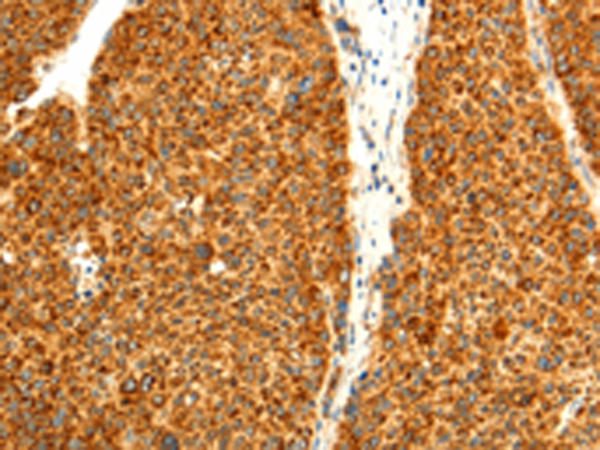
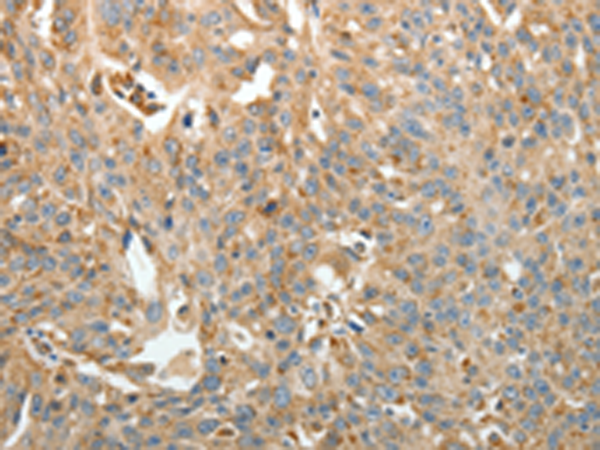

-
分类: 科研抗体货号: P07602别名: SMAC; SMAC3; DFNA64; DIABLO-S应用: WB,IHC反应种属: Human, Mouse
-
分类: 科研抗体货号: P07580别名: G0S8应用: WB,IHC反应种属: Human, Mouse, Rat
-
分类: 科研抗体货号: P07624别名: CCDC99应用: WB反应种属: Human, Mouse
-
分类: 科研抗体货号: P07579别名: XCP2; FIZZ1; FIZZ2; HXCP2; RELMb; RELMbeta; RELM-beta应用: IHC反应种属: Human
-
分类: 科研抗体货号: P07601别名: TC1; THT1; TRMA; THMD1; THTR1应用: IHC反应种属: Human
-
分类: 科研抗体货号: P07623别名: SPIN-2; TDRD26; SPIN-2B; dJ323P24.2; SPIN2_duplicate应用: WB,IHC反应种属: Human
-
分类: 科研抗体货号: P07578别名: ADSF, RSTN, XCP1, FIZZ3, RETN1应用: IHC反应种属: Human
-
分类: 科研抗体货号: P07600别名: KCC1应用: IHC反应种属: Human, Mouse, Rat
-
分类: 科研抗体货号: P07621别名: SPIN; TDRD24应用: WB,IHC反应种属: Human, Mouse, Rat
-
分类: 科研抗体货号: P07599别名: BSC1; NKCC2应用: WB,IHC反应种属: Human, Mouse, Rat

鄂公网安备42018502007531号
鄂公网安备42018502007531号

